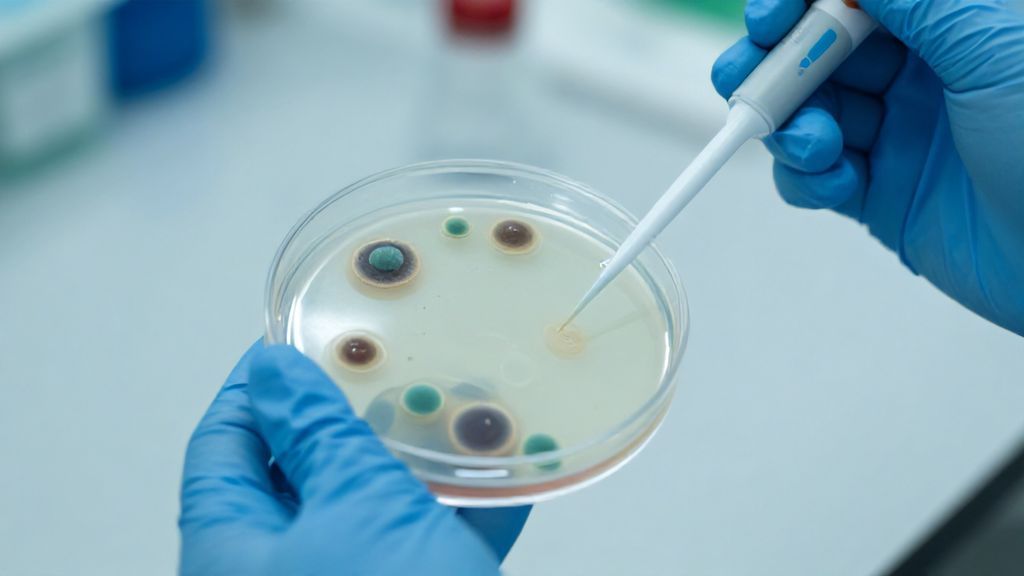
Лабораторное исследование чувствительности бактерий к антибиотикам

Acinetobacter junii в концентрации 10 в 4 степени: медицинский разбор показателя
Обнаружение в результатах анализов бактерии Acinetobacter junii часто вызывает тревогу у пациентов. Когда рядом указана цифра 10^4 (или 10 в 4 степени), возникает вопрос: является ли это опасной инфекцией или вариантом нормы? Acinetobacter junii относится к группе неферментирующих грамотрицательных бактерий, которые широко распространены в окружающей среде — почве, воде, а также могут быть частью микрофлоры здорового человека. Однако в определенных условиях этот микроорганизм способен проявлять патогенные свойства.
Для взрослого человека показатель 10^4 КОЕ/мл (колониеобразующих единиц на миллилитр) считается пограничным. В клинической микробиологии такая концентрация часто интерпретируется как колонизация — состояние, при котором бактерия присутствует на слизистых оболочках или коже, но не вызывает активного воспалительного процесса. Тем не менее, окончательный вывод зависит от места забора биоматериала и наличия жалоб.

Что такое Acinetobacter junii и откуда она берется?
Acinetobacter junii — это вид бактерий, который традиционно считался низкопатогенным. В отличие от своего «агрессивного» родственника Acinetobacter baumannii, вызывающего тяжелые внутрибольничные пневмонии, вид junii реже становится причиной серьезных эпидемий. Тем не менее, за последние десятилетия возросло количество случаев, когда именно этот вид вызывал бактериемию, перитонит или инфекции мочевыводящих путей у взрослых.
Основная особенность этих бактерий — их живучесть. Они способны длительное время выживать на сухих поверхностях, в растворах для дезинфекции и даже на коже медицинского персонала. У здоровых людей Acinetobacter junii может временно заселять кожу, ротоглотку или кишечник, не причиняя вреда, пока иммунная система работает стабильно.
Интерпретация титра 10 в 4 степени в мазках и посевах
В микробиологии существует понятие диагностически значимого титра. Для большинства биоматериалов (мазок из зева, носа, влагалища) концентрация 10^4 относится к низким или умеренным показателям. Рассмотрим подробнее значение этого результата в зависимости от локализации.
Мазок из зева и носа
В лор-практике Acinetobacter junii 10^4 часто является случайной находкой. Если у пациента нет боли в горле, налета на миндалинах или гнойных выделений, лечение антибиотиками обычно не требуется. Организм справляется с такой нагрузкой самостоятельно.
Посев мочи (уринокультура)
Для мочи общепринятым порогом инфекции считается 10^5 КОЕ/мл. Показатель 10^4 может указывать на начальную стадию цистита или на контаминацию (загрязнение) пробы при неправильном сборе анализа. Здесь врач смотрит на уровень лейкоцитов: если они в норме, терапия чаще всего не назначается.
Мазок из урогенитального тракта
У женщин Acinetobacter junii может выявляться в составе условно-патогенной микрофлоры. В титре 10^4 она редко вызывает симптомы вагинита. Однако при дисбактериозе или снижении местного иммунитета эта бактерия может начать активно размножаться, вытесняя полезные лактобактерии.

Факторы риска: когда 10^4 становится опасным
Для здорового взрослого человека Acinetobacter junii в концентрации 10^4 не представляет угрозы. Но существует категория лиц, для которых даже такой титр требует пристального внимания. Речь идет о людях с ослабленным иммунитетом (иммунокомпрометированных пациентах).
- Сахарный диабет: Повышенный уровень сахара в крови создает благоприятную среду для роста любой условно-патогенной флоры.
- Недавние операции: Ацинетобактер часто «цепляется» за поврежденные ткани или места установки катетеров.
- Длительный прием антибиотиков: Уничтожение нормальной флоры освобождает место для Acinetobacter junii, которая часто устойчива ко многим препаратам.
- Хронические заболевания легких: Бактерия может осложнять течение бронхитов или ХОБЛ.
Симптомы, требующие внимания
Само по себе число в бланке анализа не лечат. Лечат человека. Если наличие бактерии 10^4 сопровождается следующими симптомами, необходимо обсудить с врачом тактику антибактериальной терапии:
- Субфебрильная температура (37.1–37.5 °C), которая держится долгое время.
- Появление необычных выделений с резким запахом.
- Общая слабость, быстрая утомляемость и озноб.
- Признаки локального воспаления: отек, покраснение слизистых.
Важно помнить, что Acinetobacter junii обладает природной устойчивостью ко многим пенициллинам. Если врач решит, что лечение необходимо, оно должно основываться строго на результатах антибиотикограммы — теста на чувствительность, который обычно прилагается к посеву.
Методы диагностики и точность анализа
Обнаружение Acinetobacter junii 10^4 чаще всего происходит методом культурального посева (бактериологический метод). Это «золотой стандарт», позволяющий не только идентифицировать вид, но и подсчитать количество микроорганизмов.
Однако возможны ложноположительные результаты. Например, если мазок из ротоглотки брался после еды или чистки зубов, или если контейнер с мочой был доставлен в лабораторию с задержкой, бактерии могли размножиться в самой пробирке. При получении результата 10^4 при отсутствии явных симптомов часто рекомендуется пересдать анализ через 7-10 дней, соблюдая все правила гигиены и подготовки.
Профилактика и укрепление местного иммунитета
Если Acinetobacter junii была обнаружена в небольшом количестве и признана врачом колонизацией, главная задача — не дать ей превратиться в полноценную инфекцию. Для этого не нужны антибиотики, важно поддержать защитные барьеры организма.
Специалисты рекомендуют:
- Восстановление микрофлоры: Прием пробиотиков и пребиотиков помогает заселить слизистые «полезными» бактериями, которые будут подавлять рост ацинетобактера.
- Гигиена: Регулярное мытье рук и обработка поверхностей в доме (особенно если есть раны или повреждения кожи).
- Витаминизация: Поддержка уровня витамина D и цинка важна для корректной работы иммунной системы.
Для взрослых пациентов также критически важно избегать бесконтрольного приема антибактериальных препаратов «на всякий случай», так как это только закаляет Acinetobacter junii, делая её неуязвимой.

Заключение: тактика действий при результате 10^4
Подводя итог, можно сказать, что Acinetobacter junii в концентрации 10 в 4 степени для взрослого человека — это чаще всего признак носительства или временного дисбаланса флоры, а не смертельный диагноз. Паниковать при виде таких цифр не стоит. Основной алгоритм действий должен быть следующим: сопоставить результат с жалобами, оценить состояние иммунитета и, при необходимости, провести повторное исследование. Лечение требуется только при наличии клинической картины воспаления и подтвержденной диагностической значимости микроорганизма в конкретном случае.